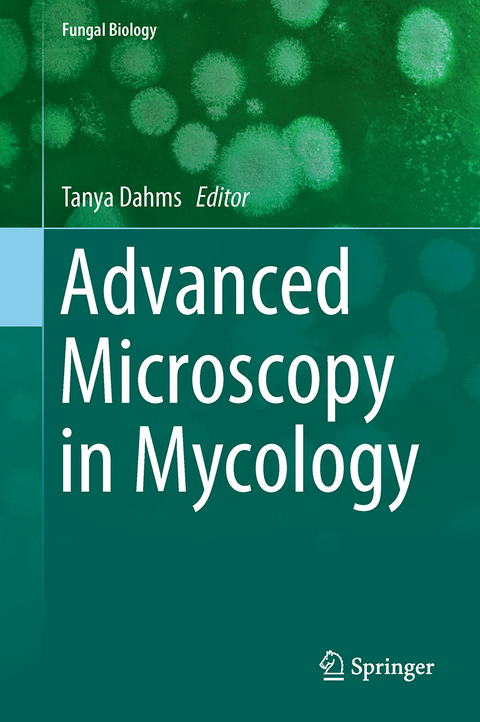
Advanced Microscopy in Mycology -

Advanced Microscopy in Mycology
Springer International Publishing (Verlag)
9783319224367 (ISBN)
Prof. Dr. Tanya Dahms serves as professor of Biochemistry and Microscopy at the University of Regina. She is head of the Dahms group, which currently studies microbial responses to external stimuli, including mechanisms associated with carbohydrate remodeling.
Applications of Confocal Laser Scanning Microscopy in Filamentous Fungi.- Fluorescence-based Methods for the Study of Protein Localization, Interaction, and Dynamics in Filamentous Fungi.- Super Resolution Microscopy: SIM, STED and Localization Microscopy.- Fourier Transform Infrared (FTIR) Microscopy and Imaging of Fungi.- Whole Cells Imaged by Hard X-ray Transmission Microscopy.- In situ Nanocharacterization of Yeast Cells Using ESEM and FIB.- Imaging Living Yeasts Cells and Quantifying Their Biophysical Properties by Atomic Force Microscopy.- Future Directions in Mycological Microscopy.
| Erscheint lt. Verlag | 6.11.2015 |
|---|---|
| Reihe/Serie | Fungal Biology |
| Zusatzinfo | XII, 164 p. 64 illus., 56 illus. in color. |
| Verlagsort | Cham |
| Sprache | englisch |
| Maße | 155 x 235 mm |
| Themenwelt | Naturwissenschaften ► Biologie ► Allgemeines / Lexika |
| Naturwissenschaften ► Physik / Astronomie ► Angewandte Physik | |
| Schlagworte | Biological Microscopy • Biomedical and Life Sciences • Cell Biology • Developmental Biology • electron microscopy • Fungioptical • Microscopy • Plant Physiology • surface scanning microscopy • yeast |
| ISBN-13 | 9783319224367 / 9783319224367 |
| Zustand | Neuware |
| Informationen gemäß Produktsicherheitsverordnung (GPSR) | |
| Haben Sie eine Frage zum Produkt? |
aus dem Bereich